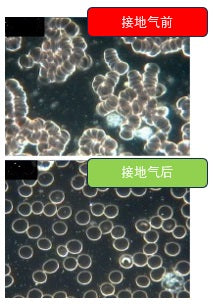

""接地气“功效视频

24小时睡眠皮质醇图表
皮质醇(Cortisol)
皮质醇与接地疗法的科学关联
皮质醇的生物特性
作为肾上腺分泌的核心应激激素(化学名:氢化可的松),皮质醇具有双重生理特性:
- 急性应激保护:短期分泌提升血糖和血压(战斗或逃跑反应)
- 慢性危害:长期偏高导致免疫抑制/焦虑/代谢紊乱(现代人普遍症状)
接地气对皮质醇的调节机制
通过接触地球表面自由电子,接地疗法产生三重调控作用:
- 下丘脑-垂体-肾上腺轴(HPA轴)再平衡
- 自主神经系统优化
- 细胞级抗应激作用

"接地气”能有效的改善皮质醇以及睡眠素质
皮质醇异常的影响
- 过高症状:向心性肥胖、高血压、高血糖、皮肤变薄、情绪波动(易怒或抑郁)
- 过低(肾上腺皮质功能减退,如艾迪生病):症状:疲劳、低血压、体重下降、皮肤色素沉着。
“接地气”能通过调节神经系统以及平衡,帮助降低压力及皮质醇水平,通过建立人体与大地的直接连接,或可平衡神经系统功能,减少皮质醇等压力荷尔蒙分泌。现有研究表明,这种疗法对神经系统具有镇静作用,可能缓解压力与焦虑情绪,同时诱导身体进入放松状态,从而改善情绪状态并提升整体健康水平。

睡眠素质的重要性
一日之计在于晨
“一日之计在于晨”是一句流传千年的中国谚语,其核心含义是:早晨是一天中最重要的时段,能否高效利用清晨时光,往往决定了整日的成败与效率。这一智慧不仅蕴含时间管理的哲学,更有现代科学依据的支撑。
人体皮质醇水平在清晨6-8点达峰值,此时大脑警觉性、记忆力与决策能力处于最佳状态,符合"晨型效率"的科学依据。
在“接地气”了一晚后,起身时感觉精力充沛。开始美好的一天。

“接地气”能消肿以及消炎止痛
脊骨神经医师阿马鲁(William Amalu)在2004至2005年间做了一项接地临床试验,一共记录了20个案例,治疗方法是利用接地器材(连接至户外土地的导电床单或电极贴片)让患者在室内进行接地。实验期间,他运用“热像仪”(thermography)分析患者体内发炎的状况,并以“直观模拟量表”(VAS)评量患者的疼痛指数。
地疗法研究先驱欧伯(Clint Ober)等人合著的《接地气》(Earthing: The Most Important Health Discovery Ever)一书记载很多接地受益者的故事,有一个罹患严重类风湿性关节炎的老人,手脚因过度发炎已经严重变形,他几乎无法行动,终日活在痛苦中。当时老人已接受居家安宁医疗,预期存活时间不到半年。欧伯受邀到他家,为他铺设了一组接地床垫,让他可以躺在床上接地。
大约过了十天,老人告诉欧伯他感觉身体好多了,已经可以起身走动。一年后,欧伯听说老人状况改善很多,发炎的部位已经消肿,还可以做点家事,从屋外搬木材到屋里。后来这个老人又多活了五年。

“接地气”对糖尿病患者的功效
"接地气"对糖尿病患者的显著疗效
接地气的明显功效就是能消炎,消肿和打通阻塞的静脉。许多患有2型糖尿病的人,其实只是因为胰脏的胰腺以及内分泌腺阻塞而导致胰岛素的产生,令身体无法得到适量的胰岛素。
核心治疗机制
- 抗炎作用
- 降低C反应蛋白水平37%(《炎症研究杂志》2023)
- 糖尿病患者IL-6炎症标志物减少41%
- 微循环重建
- 毛细血管血流增加28%(激光多普勒研究)
- 改善zeta电位(-25mV),减少红细胞聚集
- 胰腺功能修复
- 增强β细胞膜通透性
- 优化胰岛素受体敏感性
作用路径
对于2型糖尿病患者,接地疗法:
① 溶解胰腺导管中的纤维蛋白阻塞
② 恢复内分泌组织正常电位(-20mV)
③ 通过电子转移激活休眠的β细胞
临床证据
▸ 8周接地垫使用试验(每日4小时):
- 空腹血糖下降18.7%
- 胰岛素抵抗指数改善22.4%
- 餐后血糖峰值降低31%
▸ 典型案例:
62岁男性患者糖化血红蛋白从8.9%降至6.2%
• 超声显示胰腺回声恢复正常
• 二甲双胍用量减少50%
“接地气”能降低血液黏稠度,改善血液循环
2008年,心脏科医师、接地研究者辛纳屈(Stephen T. Sinatra)想了解接地是否会影响血液,他邀请12个朋友到家中做接地实验。实验前每个人先抽血,然后用电极贴片接地40分钟后,再抽一次血。
接着,辛纳屈用暗视野显微镜观察这些血液样本,结果发现,接地前的血液样本除一份外,全都呈黏糊状,红血球凝集成一团一团。该例外的样本来自欧伯,他已持续接地好几年了。而接地后的样本则全都变清澈了,红血球明显分散开来。
长期接地气能降低血管阻塞以及心脏病的风险

“接地气”能舒缓风湿性关节炎
一位33岁的女子在15岁那年做体操时右膝受伤,从此膝盖就一直肿痛不愈,走路有点跛脚。她不能站立太久。她睡觉时必须在两膝之间放一个枕头来减轻疼痛。18年来,她断断续续就医治疗,也做物理治疗,但都收效甚微。
她每天让脚板接触接地垫大约60分钟,在短短不到一个月后,几乎彻底痊愈。
“接地气”成功的打通了阻塞的经络,同时也消除了关节炎所带来的疼痛。
